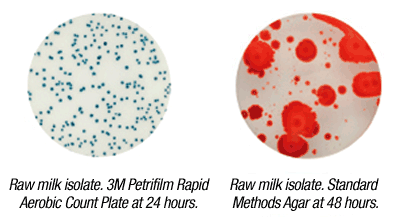

Diese schnellen aeroben Gesamtkeimzahl-Platten bedeuten einen Schritt nach vorn bei der Sicherstellung von Qualität und Sicherheit der Produkte von Lebensmittelherstellern
Die 3M-Petrifilm-Gesamtkeimzahl-Platte ist der unverzichtbare Indikatortest zur Messung der Niveaus an Mikroorganismen in Lebensmitteln und Lebensmittelherstellungsbereichen, der Unternehmen dabei unterstützt, die Qualität sicherzustellen und den Verderb von Lebensmitteln zu reduzieren und gleichzeitig die schnellen, präzisen Zählungen zu erzielen, die für zeitkritische Entscheidungen über Qualitätskontrolle und Korrekturmaßnahme entscheidend sind.
Verdorbene Lebensmittel können durch aerobe Bakterienpopulationen in Lebensmittelrohstoffen, Produkten und Fertigungsumgebungen nachgewiesen werden. Aerobe 3M Petrifilm-Gesamtkeimzahl-Platten leisten diesen Test schnell und präzise.
Aerobe 3M Petrifilm-Gesamtkeimzahl-Platten sind ebenso zuverlässig wie die Standard Method Agar (SMA)-Plattenmethode. Das Produkt hilft Agarbenutzern dabei, teure Nachtests und verzögerte Ergebnisse durch Interpretationsprobleme aufgrund von Spreader-Kolonien zu vermeiden.
3M Petrifilm-Gesamtkeimzahl-Platten enthalten Nährstoffe und ein in kaltem Wasser lösliches Geliermittel. Die Indikator-Technik ermöglicht das Auszählen von Kolonien in 24 Stunden bei fast allen Lebensmittelarten (außer Milchpulver). Schnellere Ergebnisse und weniger Arbeit bedeuten, dass die Beschäftigten in der Nahrungsmitteldienstleistungsindustrie mehr Zeit zum Überwachen von Prozessen haben, wodurch engere Prozesskontrollen und ein hochwertigeres Produkt sichergestellt werden. Die aeroben 3M Petrifilm-Gesamtkeimzahl-Platten für Schnelltests (Rapid Aerobic Count Plates) geben Fachkräften in der Nahrungsmitteldienstleistungsindustrie zudem die Beruhigung, dass sie alles Mögliche tun, um ihre Kunden und ihren Ruf zu schützen.
Die aeroben 3M Petrifilm-Gesamtkeimzahl-Platten zählen die Gesamtzahl aerober Bakterien in der Probe. Sie können außerdem zur Zählung anaerober Bakterien in verarbeiteten Fleischwaren sowie in stark säurehaltigen Lebensmitteln verwendet werden.
Das schnelle und präzise Testen mit den aeroben 3M Petrifilm-Gesamtkeimzahl-Platten erfordert nur drei Schritte. Zuerst inokulieren Sie die Platte mit einem Milliliter der Probe und verwenden den Probenverteiler. Dann inkubieren Sie bei der geeigneten Temperatur (32° C oder 35° C).
Nach der Inkubationszeit zeigen sich die Kolonien entweder als Kleckse oder Flecken, die von Blasen umgeben sind. Das ist je nach Art der Mikroorganismen unterschiedlich.
Der letzte Schritt besteht darin, die Kolonien zu zählen — eine Indikatorfarbe auf der Platte färbt alle Kolonien und vereinfacht das Zählen. Außerdem macht eine Schaumbarriere um den Inokulationsbereich das Inokulieren der Platten noch einfacher. Damit können Sie einen breiten Bereich an Lebensmitteln abdecken und alle Lebensmittel testen.
Die aeroben Petrifilm-Gesamtkeimzahl-Platten für Schnelltests von 3M zeichnen sich im Gegensatz zu anderen SMA-Methoden durch bewährte Zuverlässigkeit aus. Zudem kann das Produkt für die Entnahme von Umweltproben über Luft, Tupfer oder Oberfläche verwendet werden, ohne dass eine arbeitsintensive Medienvorbereitung erforderlich ist.
Bildquelle: 3M
